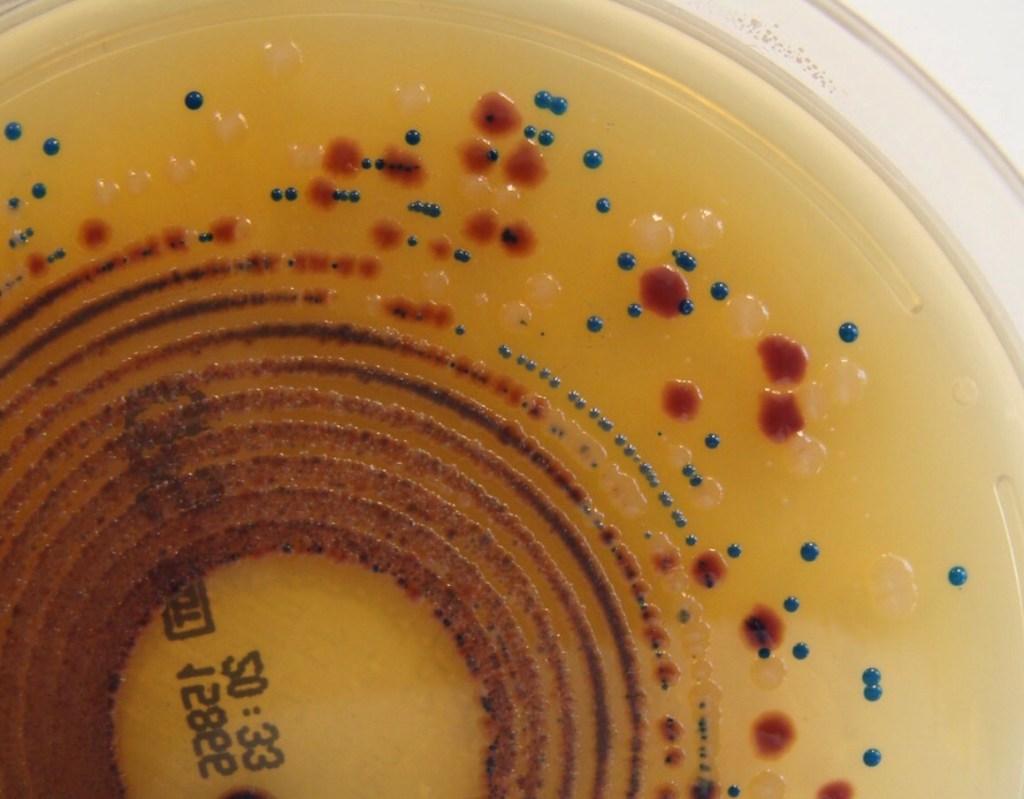

I love y’all, but yer crazy.
To the wonderful men and women across North Dakota, America and the globe who are lining up for their chance to get the shot or who are lining up their children to get the shot, “What on earth are you thinking?”

This is gonna be a long one, so here’s a list:
It’s experimental
It *might* work
The human studies are very questionable
It might mess with your insurance
NCVIA grants legal immunity to the manufacturer
Submitting a VAERS claim is nearly impossible
There are other possibly safer vaccine options
The animal studies are very questionable
The possibility for altering your DNA is 100% there
The exact contents are unknown but we do know that-
It’s made from poop and baby parts
Vaers only accounts for 1% of adverse reactions
There’s a 366% increase in pre-born infant deaths due to the mRNA vaccines.
Vaccines cause an immune response, as does poison.
The things we are told don’t make sense
Finding actual truth is hard work, lots of scientists don’t do it
Animated models based on assumptions rule
Humans and animals are messy
Labs have frequent safety and health violations
Labs have cross contamination
Vaccines have cross contamination
Ebola and Covid and HIV (oh my)
Antibody dependent disease enhancement
Blood clots,heart attacks and autoimmune diseases anyone?
Isn’t natural immunity healthier?
Shouldn’t the cure be less painful than the disease?
Why are you accepting these things? How can you ignore all of this?
To begin with, the Covid-19 vaccine is available to the public through an Emergency Use Authorization because it is still an experimental treatment. It has not been approved by the FDA for regular use in humans. It hasn’t even been approved for regular use in animals.

An Emergency Use Authoriztion is provided by the FDA “when there is a declared emergency, the FDA can make a judgment that it’s worth releasing something for use even without all the evidence that would fully establish its effectiveness and safety.” According to the FDA’s own regulations, an EUA is issued only when the experimental treatment has a “strong track record through at least a median of two months of follow-up time.” This minimum standard appears to have been dropped. The first vaccine to receive the FDA’s EUA was Pfizer’s. Pfizer’s track record only covered 7 days, not two months. Regardless, the EUA vaccine treatments are still classified as experimental according to the National Institute of Health and multiple other sources, such as the US Military.

A problem few are recognizing is, that at the very least, experimental treatments may have unwanted effects on your health insurance and life insurance. “A favorite excuse of insurance carriers is that the treatment is “experimental and there is not enough evidence showing that the treatment is safe and effective. …[Even with] such evidence, insurers justify their denials by setting a high threshold in their policies for a treatment not to be considered experimental.”

If you have an insurance policy, you need to read it’s rule on experimental treatments. Most life insurance policies and health insurance policies deem a treatment experimental if it has not completed the FDA requirements for phase 2 and phase 3 trials. Many SARS-Cov-2 “vaccine” treatments are still in phase 1. Pfizer is still in the midst of it’s phase 2 and phase 3 trials. Moderna just announced the beginning of a phase 2 trial this week.
The experimental vaccines themselves were purchased by the federal government (read manufacturers already got paid) and made available to the public. Your insurance will pay a fee for the medical service of receiving the vaccine. However, should you develop a severe illness or die following your vaccination, these costs may not be covered. Most experimental medical treatments are the legal equivalent of suicide, according to many an insurance company.
If you do have an adverse reaction, you can report it through the VAERS system. The VAERS system was created through the National Vaccine Childhood Injury Act in 1986. Vaccines were legally declared so important, that vaccine manufacturers shouldn’t be bothered with being held legally accountable for vaccine injuries. Imagine if this applied to another manufacturer. If you smoked cigarettes in front of your child and your child died of lung cancer, Camel would not be legally accountable for the death of your child.

Why? Cigarettes are too important to society. That’s the policy that runs America’s vaccine industry. Of course, finding a doctor willing to make a VAERS report on your behalf is next to impossible. Without doctor’s backing, your VAERS claim will not result in financial support.
Pfizer, Moderna, Astra-Zenica, Johnson & Johnson and many other companies have developed experimental treatments, all similar but different, that address the singular problem of Severe Acute Respiratory Syndrome resulting from infection by Covid-19, or Coronavirus 2. SARS-Cov-2 treatments are “experimental biologics,” AKA vaccines. If we truly understood the mechanisms of infection and immunity, there would be a single solution. There isn’t.
Vaccine companies have legal immunity from any medical outcomes. To date, not a single one of these treatments meets the legal definition of a vaccine. A “vaccine is a formulation intended to be administered for the purpose of inducing an immune response specifically directed to the prevention or treatment of a disease state, or symptoms caused by an infectious agent.” According to the Mayo Clinic the experimental Covid-19 vaccines might do the following:

Is that true though? According to Pfizer and Moderna the phase 1 study demonstrated a reduction in one, only one, of any of the possible symptoms of Covid-19, and called that success.

According to CBS News “Pfizer and its German partner BioNTech previously reported the shots appear 95% effective at preventing mild to severe COVID-19 disease in a large, ongoing study. That’s based on the first 170 infections detected. Only eight of the infections were among volunteers given the real vaccine while the rest had received a dummy shot.”
The biggest problem with these claims is that when you look at the actual study data, it’s just not true. There’s the issue of the math:
There’s also the issue of the “preventing mild to severe COVID-19 disease.” I don’t know about you, but to me, a decrease in just one symptom doesn’t sound like it is doing anything more than lessening mild COVID-19 disease.
Why would they put forth a vaccine with such faulty data? Wouldn’t Pfizer know? Wouldn’t the FDA or the CDC know? Yes. But then there wouldn’t have been so much money made. Yes, money. Please note the CDC is not only a government agency. It is also a business. “Established by Congress as an independent.. organization, the CDC Foundation is the sole entity authorized by Congress to mobilize philanthropic partners and private-sector resources.”

It is also a business whose employees own patents for not only the vaccines but also for the viruses themselves.
The FDA, the legal government body in charge of authorizing medical treatments, doesn’t do any of their own research, investigation, or verification of the facts which are provided by the for profit corporations. The manufacturer itself is responsible for producing the “facts” which prove their own product is safe and effective.

The majority of EUA Covid-19 vaccines are based on mRNA techniques, the heralded new frontier in health cures. Yet, when Stéphane Bancel CEO of Moderna reportedly asked Tal Zaks, CMO of Moderna “Is this gonna work?”, Zaks replied, “I don’t know, but we’ve got all the pieces to try… so we should try.” Again, I don’t know about you, but to me, that’s not a great indicator that this is gonna work.
In his 2019 Ted Talk, Tal Zaks receives a standing ovation for stating that mRNA vaccines will cure cancer, because they change DNA. Zaks also discusses his landmark 2017 study proving that mRNA vaccines are safe and effective. However, when we look at the actual study, we see a different picture.

Initially note that the title of the study references “immunogenicity” which is not the same thing as immunity. Immunity means you are protected from a specific thing. Immunogenicity means that your immune system was triggered- you got sick. According to study.com, “a great example of immunogenicity is vaccination.” Another great example is poison. A key difficulty with vaccination studies is that an immune response can be observed, fever, chills, malaise, but determining if that result’s in immunity to a specific virus… That is mostly unknown. At best, it’s a balance of educated guesses.
The 2017 Immunogenicity via mRNA study covered three animals, mice, ferrets and non-human primates. (I’m only going to discuss the mice portion of the study because, otherwise, we will be here all week. And quite frankly, there’s not as much data in the study on the other two animals. Which should make you wonder why. But I digress.) 15 mice were experimented on, but the results included in the paper did not cover all 15 mice. Why? This information is not revealed. We just don’t know. We do know that only three mice received the full series of diagnostic analysis and tests. There are multiple additional problems with the study.

A control group received inactivated virus as a placebo. Which is not actually a placebo but a different method of vaccination. So when Tal Zaks says, “The adverse reactions were not unusual,”
he is comparing an mRNA injection to H7N9 (which has a roughly 41% death rate in humans) and to H10N8 (which has a 60% death rate in humans).
When later, all mice were infected with a “lethal dose of influenza” the control animals did demonstrate an immune response similar the experimental mRNA group. However, the control group mice had more severe weight loss. This was recognized as lethal, although the mice did not die. I imagine the authors said something along the lines of “Well, they lost a lot of weight, so like, the mice, were like, almost dead, kinda.” At least one of the high weight loss mice was euthanized. Such mice then could have been utilized to compare tissue samples with the mRNA group. They were not.

Interestingly, the authors state, “Additionally, it is not possible to rule out a low level of protein expression from the de-methylated cap of the negative mRNA control.” Which is to say, “Hey, maybe the safer technique of using an inactivated virus (what the control group got) actually works.”
As it was also noted that not all mRNA vaccination equals immunity, there must have been some animals experimented on that did not develop the desired immune response. “Indiscriminate immune activation can inhibit mRNA translation, reducing antigen expression and subsequent immunogenicity.” This may be why there were 15 mice in the study but there are only data sets for 6 and only three were analyzed post-mortem.

The mice were given 14 days to have an immune response to the “lethal dose.” Then, three were euthanized. After euthanasia, the three mRNA vaccinated mice were sliced and diced for study. The tissues were then examined for presence of the “modified mRNA-based influenza A vaccine”. It was found in every single bodily tissue examined. From brains to testes, the mRNA (which is supposed to quickly degrade) was present, more than 80 days after injection AND it had spread all over the bodies of the three mice.
The study authors did not see any issue with this. Even knowing that the function of mRNA is to change DNA, the expert scientists had no issue with their newly created modified messenger-RNA being found in the nervous system, the circulatory system, the respiratory system, the reproductive system, the muscular system, the digestive system, the skeletal system, even within bone marrow. Why? 1) The animals didn’t die… in the whopping 84 days since vaccination nor during the incredibly long 14 days after exposure to the challenge virus. Though they did eventually die, well before the average end of a mouse’s life. 2) They, of course, want their idea to work. It is their big idea and it’s going to make them tons of money.
Even NPR noticed that Moderna executives sold giant swaths of stock after MRNA began it’s 2020 sky rocket in market value. While these individuals did not sell at exactly the highest peak of the MRNA stock value $185, they did sell after their previously $12 stocks had risen to over $130. The CEO alone, earned almost 2 million from just stock sales in 2020– more than tripling Bancel’s personal net worth.

Well, but, you might say, “There’s nothing wrong with a person or business earning money for a product they’ve created.” And you’re right, there’s not, unless that person or business is making a product that may hurt others, and there’s zero chance that they would be held liable. Then, I believe we have a problem. Moderna, and other corporations like it, have been given the green light to do as they please. Much like our governments have granted themselves unlimited “emergency powers” because it’s an “emergency,” vaccine manufacturers have been granted unlimited ability to create and disseminate medical treatments without a single legal check or balance.
Covid-19 is a perfect example of the unchecked hubris of medical R & D. Do we know exactly what is in each of the Emergency Use Authorized vaccines available? No, we don’t. It takes quite a bit of reading to discover some of what’s inside the vaulted “shot that’s saving humanity.”
To begin with, we know that it’s genetically modified messenger-RNA. Generally speaking, RNA is roughly half of a DNA, it’s made with similar ingredients, and it bosses DNA around. (Kind of like a certain three-year old I know, small and bossy.). What did they do with the RNA to modify it? They began with adenovirus RNA and added the “spike” protein from coronavirus to it.
Wanna know where the adenovirus cells come from??? Poop. Yup, that’s right, your life changing vaccine, that’s not a vaccine, but rather an experimental treatment, is made from Chimpanzee poop. Okay, so it’s not like the injection is brown, but well… (Can you tell I’m a mother of boys?) That’s the initial source. It’s called ChAdOx1 or Ad5. The adenovirus is extracted from Chimpanzee fecal material.
Then (basically) the adenovirus is broken and flooded with spike proteins extracted from coronavirus, SARS-Cov-2. It is assumed to utilize the spike protein to repair itself. Now you have adenovirus plus a spike protein. The final steps are copy and clean up.
The broken ‘extract of chimp-poo’ that has scabbed over with Covid spikes are grown in a lab using HEK 293 cloned cells from a 1970s human foetus. Which is of course nothing like actual baby tissue. (ahem) Not now, anyway. It’s more like cancer cells actually.
HEK 293 cells were obtained from an aborted infant in the 1970s. The reason we can still use them is that they were modified so that they would grow exponentially, ya know, like cancer. Anyway… the ChAdOx1 (or Ad5) + Spike protein cells are replicated, copied, grown on HEK 293. We are assured, “after they are grown, the viruses are purified several times to remove the cell culture material. This makes it unlikely that any human material remains in the final vaccine.”
While we are using aborted human foetus cells (aka baby parts) for the creation of this new experimental medical treatment, it’s important to note how incredibly dangerous receiving the vaccine is for pregnant mothers. Reports of intra-uterine infant death (miscarriage, now called spontaneous abortion) after receiving “the jab” in England, show a 366% increase. Within the United States, the Vaccine Adverse Event Reporting System, and social media personal accounts show similar results.
Vaccines are big business all over America and around the world. Both manufacturers and your local health care provider are very well paid.

Further, insurance is tied to a high rate of vaccine compliance. Any doctor willing to stand up for a patient who has had a vaccine injury, or “adverse event”, has a significant of risk of losing their insurance coverage and then their license to practice medicine. This is one of the many reasons why the VAERS system is known to only catch 1% of vaccine injuries.

1% – The current rate of Covid-19 vaccine adverse events is 38,444 out of 95,744,718 as of 3/11. That means 1% of actual reactions to the mRNA Covid-19 shot is 4 adverse events per 1000.
Based on this data, in actuality there are 4 adverse events for every 10 mRNA Covid-19 injections.
The information from VAERS where death is the adverse event in question is: 1739 out of 95,744,718 as of 3/11/21 or 1.8/100,000. Again, this is recognized as just 1% of the IRL total.
Thus, 1.8 deaths for every 1000 mRNA Covid-19 injections.
I have had many people say to me, that they don’t know anyone who died after receiving the experimental treatment. To which I want to say, “Well, I don’t know 1000 people, do you?” I’ve also heard, “Look, I don’t want to fight this anymore. I’m going to die when God says it’s my turn.” To which I want to say, “So living with a life-altering disease, like my friend who was diagnosed with Gillan-Barr Syndrome after a flu vaccination, and spends her life nearly immobile, unable to control her own body, is the way you’d like to live?” Or perhaps, “Just because God’s in charge of your time of death doesn’t mean you need to jump of the roof.” I’m sure my neighbors thank me for keeping my mouth shut.
See the thing is, vaccines create an immune response. So does poison. So do a lot of things. Looking at the historical polio virus samples, virology researchers found that only about 1/3 of the children with confirmed polio cases truly had the polio virus. What did the remainder have? Primarily, poisoning from substances like DDT, that we didn’t know hurt people. Going back to the Immunogenicity study of H10N8 and H7N9, the mice who survived were regularly exposed to the virus and they maintained a moderate level of antibodies showing an immune response. Yet, the researchers didn’t consider that the antibodies were in response to the repeated exposures to H10 or H7. They assumed it was due to their creation.

Which brings us back to the question of what we know and what we don’t know. We don’t know how mRNA distributed all over your body will react to future events. We are told that not only do you need the Covid vaccine, you may need one every three months and for every variant of the virus. SARS-Cov-2 is not the same as SARS-Cov. Yet, there are multiple studies showing that one vaccine can provide immunogenicity for a variety of viral strains. Like this one in humans, and this one in animals. The animal study is more detailed. After vaccination against H1N1, the study showed an “induced effective seroconversion and virus-neutralizing antibodies in all vaccinated animals. Immunity was long lasting and protected both young and old animals from lethal challenge with the H1N1, H3N2, and H5N1″
Things are not adding up. We are told the mRNA has to be wrapped in liquid PEG nanoparticles or it will fall apart and not work. We are told they have to be super frozen or they will rot within an hour. Yet, after 80+ days, the mRNA was found intact all over the warm bodies of the mice. This is seen in multiple studies.
We are told that the vaccines are safe because the V-safe program was created to catch adverse events. Notice it doesn’t say prevent them. The V-safe program does not actually provide any increase in safety.

Fitting with the entire field of immunization, manufacturing V-safe only asks for certain data- have you had a fever, chills, etc? It does not ask of you have developed an autoimmune disease. It does not ask if you have had a heart attack. It perfectly mirrors the machine that seeks to create immunogenicity not immunity. Why? They don’t have to. They are not legally responsible if the flu vaccine does not protect you from the flu.

Creating immunity is still beyond our scientific understanding. We can observe cause and effect, inject something and the body gets sick to varying degrees. BUT we don’t know exactly what’s happening inside us at a cellular level. All those amazing molecular videos? They are cartoons based on what someone thinks happens.
We are so enamored with cultural pride in our knowledge, that we aren’t asking if what we know is true. We aren’t dealing with the glaring red flags that shine a light on our cultural failures. For example, when I think about a molecular biology laboratory studying infectious diseases, I imagine a pristine, white, sterile space where not a single speck of germs are found. The reality is quite the opposite. Labs are not as clean as you think. Frequent health and safety violations are pretty normal.

“A USA TODAY Network investigation reveals that hundreds of lab mistakes, safety violations and near-miss incidents have occurred in biological laboratories coast to coast in recent years, putting scientists, their colleagues and sometimes even the public at risk.
Oversight of biological research labs is fragmented, often secretive and largely self-policing, the investigation found. And even when research facilities commit the most egregious safety or security breaches — as more than 100 labs have — federal regulators keep their names secret.”

Just like wearing latex gloves to protect your body from germs, and then scratching yer … with them, then rubbing your eye. We are human. Humans are dirty. Humans running animal experiments are gonna be even dirtier. Thus, vaccines are often “dirty” as well.
The most well known contaminated vaccine example is “the presence of SV40 in monkey cell cultures used in the preparation of the polio vaccine from 1955 through 1961.” The contaminated “polio vaccine became contaminated with a cancer-causing virus carried by these monkeys. This vaccine was given to almost 100 million people.” It is believed that more than 40 million Americans developed cancer as a result.
This isn’t just a tale of the past though. A 2020 MIT and Nature Biotechnology study confirmed, the “use of cell culture to produce recombinant proteins is still susceptible to contamination.” This study also confirmed there have been “26 virus contaminations [found in vaccines] over the past 36 years.” The study does not investigate any other forms of contamination, like bacteria or “human foetal tissue.” (Note: Researchers used the spelling foetal in the hope that you won’t notice that they are discussing babies.) Vaccines do often have other unintended contaminants like bacteria. This study found bacteria and endotoxins in 18 out of the 20 vaccines checked.
Did you know that the same laboratories and often the same researchers that study and experiment on the mRNA virus SARS-Cov-2, also study and experiment on the mRNA viruses HIV and Ebola? Or that they use the same ingredients? ChAdOx1 and Ad5 are used as the basis for most of the vaccines created for all three. In the past, HIV vaccine research was stopped due to contamination causing healthy individuals to acquire HIV after vaccination. Which is the same trend noticed post Covid-19 vaccination, infection with the disease the vaccine is intended to prevent.
Personally, I don’t understand how people cannot worry about the possible effects of a Covid-19 vaccine contaminated with Ebola. It’s not hard (IMHO) to see the connection when there are articles like these:
Even the CDC Covid-19 protocols reference Ebola. Did you know that the crown (corona) of spikes present on a SARS-Cov-2 particle are also on Ebola and HIV? Might a Covid-19 vaccination based solely on mRNA and spike proteins have negative consequences if a person encounters HIV or Ebola? Well, we just don’t know. We do know that scientists are trying to develop an infectious vaccine.

Huh? A vaccine that will intentionally be spread like a virus. Then even those who make the medical choice that their own personal body won’t receive an experimental medical treatment will still “be vaccinated.”
The idea isn’t actually that radical. We already know that vaccines “shed.”

Of course the above studies did not investigate if the viruses spread to others, only if it was possible. To assess shedding scientists need to both verify that person A shed viral particles after vaccination, AND that it spread to others. This would be a lot of work. It is also very much beyond our current scientific capabilities. We do not have the ability to prove that person A made person B sick.
Now, seriously, this is getting very, very long. I apologize. We haven’t even gotten through half of my list of concerns. So, I’m going to drop the analysis of more medical research and just leave you with a few remaining questions. Things you can look into for yourself perhaps. (Please?)
What about Antibody Dependent Disease Enhancement?

What about the 18 countries that have stopped the Astra-Zeneca Covid-19 vaccinations?

What about the Hippocratic Oath, “First do no harm”? Shouldn’t the cure be less painful than the disease? The November 2020 Covid-19 death rate in North Dakota, internationally recognized as the “highest in the world” was maybe 1 in 1,129. Of course, we have since been shown that these numbers didn’t reflect reality.

Well, I had more points left but life (aka motherhood) calls. To end with, I just want to ask, “How can you ignore all of this? Any of this?”
Things left un-discussed:
“There were concerns seen in animal studies with earlier coronavirus vaccines for SARS-CoV-1 and MERS. But not in human studies to date.” But the reason there have been no “human studies to date” is that long-term animal trials have always resulted in many or all of the animals dying.
When the Human Guinea Pig Vaccine Takers Start Dying, It’s Straight to Nuremberg
Biosafety Laboratories 3&4
Covid: For decades, scientists have been hot-wiring viruses in hopes of preventing a pandemic, not causing one. But what if …?
https://www.eyeopeningtruth.com/covid-19-more-than-you-ever-wanted-to-know-about-bio-weapons/
https://eddiesbloglist.rocks/date/2020/05/23/
https://www.liquisearch.com/biosafety_level/list_of_bsl-4_facilities
“Wuhan’s BSL-4 lab, which opened in 2017, studied the Ebola and HIV viruses before tackling the new coronavirus.”
https://www.wsj.com/articles/chinas-reckless-labs-put-the-world-at-risk-11614102828
https://www.yahoo.com/news/diplomats-warned-coronavirus-danger-wuhan-043020270.html
Bsl-4 lab locations. https://www.channelnewsasia.com/news/singapore/dso-biosafety-lab-lethal-viruses-biological-threats-14305718
https://www.usatoday.com/story/news/2015/05/28/biolabs-pathogens-location-incidents/26587505/
All animals in mRNA studies died within 4.3 human equivalent years
Lab scientists poop in their hazmat suits?
Despite high vaccine-induced antibody titres, none of the vaccines protected lungs completely from apparent gross pathology.
https://www.microbiologyresearch.org/content/journal/jgv/10.1099/vir.0.2008/001891-0#tab2
If you made it this far, wow! You deserve a cookie!











[…] correlation between requiring shoes and shirt is in no way comparable to mask or an injection. Nor and injection that may result in death or severe life-long disability. Shirts and shoes do not cause death. There is no legal ability of a school or business to force […]
LikeLike